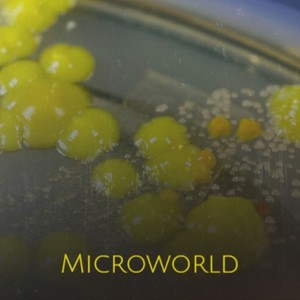
Eye to the Sun

Kenneth W. Lovell Jr
热门歌曲
-
Kenneth W. Lovell Jr 1.14 MB 01:14
-
Kenneth W. Lovell Jr 4.6 MB 05:01
-
Kenneth W. Lovell Jr 2.88 MB 03:08
-
Kenneth W. Lovell Jr 3.67 MB 04:00
-
Kenneth W. Lovell Jr 1.28 MB 01:23
-
Kenneth W. Lovell Jr 2.41 MB 02:37
-
Kenneth W. Lovell Jr 2.78 MB 03:02
-
Kenneth W. Lovell Jr 2.26 MB 02:27
-
Kenneth W. Lovell Jr 954 KB 01:00
-
Kenneth W. Lovell Jr 2.22 MB 02:25
-
Kenneth W. Lovell Jr 2.41 MB 02:38
-
Kenneth W. Lovell Jr 1.65 MB 01:48
-
Kenneth W. Lovell Jr 1.08 MB 01:10
-
Kenneth W. Lovell Jr 964 KB 01:01
-
Kenneth W. Lovell Jr 1.56 MB 01:42
-
Kenneth W. Lovell Jr 1.13 MB 01:14
-
Kenneth W. Lovell Jr 1.42 MB 01:33
-
Kenneth W. Lovell Jr 5.27 MB 05:45
-
Kenneth W. Lovell Jr 1.26 MB 01:22
-
Kenneth W. Lovell Jr 4.54 MB 04:57
-
Kenneth W. Lovell Jr 2.73 MB 02:58
-
Kenneth W. Lovell Jr 2.41 MB 02:37
-
Kenneth W. Lovell Jr 1.07 MB 01:09
-
Kenneth W. Lovell Jr 2.96 MB 03:13
-
Kenneth W. Lovell Jr 2.13 MB 02:19
-
Kenneth W. Lovell Jr 2.48 MB 02:42
-
Kenneth W. Lovell Jr 2.01 MB 02:11
-
Kenneth W. Lovell Jr 2.63 MB 02:52
-
Kenneth W. Lovell Jr 2.45 MB 02:40
-
Kenneth W. Lovell Jr 1010 KB 01:04
-
Kenneth W. Lovell Jr 601 KB 00:38
-
Kenneth W. Lovell Jr 2.12 MB 02:18